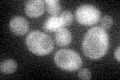
YPL161C
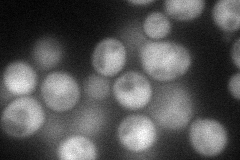
YPL161C
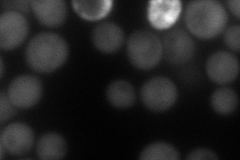
YPL161C
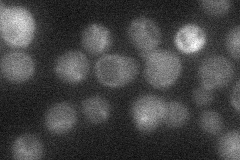
YPL161C
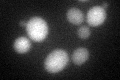
YPL161C

View description
Protein involved in establishment of cell polarity and bud emergence; interacts with the Rho1p small GTP-binding protein and with the Rho-type GTPase Cdc42p; involved in maintenance of proper telomere length
Localization:
Intensity:
Fold change:
Significance:
-
C’ GFP library in SD
cytosol25.51 -
N' NOP1pr-GFP in SD
cytosol73.4367 -
N' TEF2pr-mCherry in SD
cytosol76.9098 -
N' NATIVEpr-GFP in SD
below threshold29.4642 -
N' TEF2pr-VC and Cyto-VN in SD

#N/A0 -
C’ GFP library in SD+DTT
cytosol26.181.02No -
C’ GFP library in SD+H2O2

cytosol29.311.14No -
C’ GFP library in Starvation Media

cytosol32.551.27No -
C’ GFP library on the background of Pup2-DaMP

cytosol -
C’ GFP library on the background of CCT mutant

cytosol28.51661.11775No
